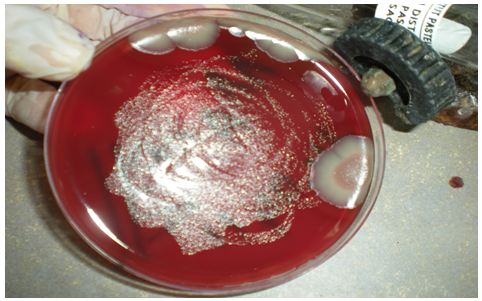

Les milieux ensemencés et mis à l’étuve à 37°C en atmosphère microaérophile, sont observés tous les deux jours pour détecter une éventuelle croissance de colonies suspectes : petites (environ 1mm de diamètre) et translucides. (Figure n°17)
Figure n°17 : Helicobacter pylori en primo-culture (photo prise au laboratoire de bactériologie, de l’EPH Bologhine Ibn Ziri).
L’identification repose sur les conditions de culture (notamment la microaérophilie), et sur les caractères morphologiques et biochimiques. Elle comprend les étapes suivantes :
Page suivante : 3-6-1- Réalisation d’un frottis coloré par la méthode de Gram :